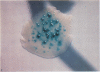
2710

Abstract
We have used a strain with an altered lacZ gene, which reverts to wild type via only certain transversions, to detect transversion-specific mutators in Escherichia coli. Detection relied on a papillation technique that uses a combination of beta-galactosides to reveal blue Lac+ papillae. One class of mutators is specific for the G.C----T.A transversion as determined by the reversion pattern of a set of lacZ mutations and by the distribution of forward nonsense mutations in the lacI gene. The locus responsible for the mutator phenotype is designated mutY and maps near 64 min on the genetic map of E. coli. The mutY locus may act in a similar but reciprocal fashion to the previously characterized mutT locus, which results in A.T----C.G transversions.
Full text
PDF




Images in this article
Selected References
These references are in PubMed. This may not be the complete list of references from this article.
- Bachmann B. J. Linkage map of Escherichia coli K-12, edition 7. Microbiol Rev. 1983 Jun;47(2):180–230. doi: 10.1128/mr.47.2.180-230.1983. [DOI] [PMC free article] [PubMed] [Google Scholar]
- Choy H. E., Fowler R. G. The specificity of base-pair substitution induced by the mutL and mutS mutators in E. coli. Mutat Res. 1985 Mar;142(3):93–97. doi: 10.1016/0165-7992(85)90046-6. [DOI] [PubMed] [Google Scholar]
- Coulondre C., Miller J. H. Genetic studies of the lac repressor. III. Additional correlation of mutational sites with specific amino acid residues. J Mol Biol. 1977 Dec 15;117(3):525–567. doi: 10.1016/0022-2836(77)90056-0. [DOI] [PubMed] [Google Scholar]
- Coulondre C., Miller J. H. Genetic studies of the lac repressor. IV. Mutagenic specificity in the lacI gene of Escherichia coli. J Mol Biol. 1977 Dec 15;117(3):577–606. doi: 10.1016/0022-2836(77)90059-6. [DOI] [PubMed] [Google Scholar]
- Cox E. C. Bacterial mutator genes and the control of spontaneous mutation. Annu Rev Genet. 1976;10:135–156. doi: 10.1146/annurev.ge.10.120176.001031. [DOI] [PubMed] [Google Scholar]
- Cox E. C. Mutator gene studies in Escherichia coli: the mutT gene. Genetics. 1973 Apr;73(Suppl):67–80. [PubMed] [Google Scholar]
- Duncan B. K., Miller J. H. Mutagenic deamination of cytosine residues in DNA. Nature. 1980 Oct 9;287(5782):560–561. doi: 10.1038/287560a0. [DOI] [PubMed] [Google Scholar]
- Duncan B. K., Rockstroh P. A., Warner H. R. Escherichia coli K-12 mutants deficient in uracil-DNA glycosylase. J Bacteriol. 1978 Jun;134(3):1039–1045. doi: 10.1128/jb.134.3.1039-1045.1978. [DOI] [PMC free article] [PubMed] [Google Scholar]
- Eisenstadt E., Warren A. J., Porter J., Atkins D., Miller J. H. Carcinogenic epoxides of benzo[a]pyrene and cyclopenta[cd]pyrene induce base substitutions via specific transversions. Proc Natl Acad Sci U S A. 1982 Mar;79(6):1945–1949. doi: 10.1073/pnas.79.6.1945. [DOI] [PMC free article] [PubMed] [Google Scholar]
- Foster P. L., Eisenstadt E., Miller J. H. Base substitution mutations induced by metabolically activated aflatoxin B1. Proc Natl Acad Sci U S A. 1983 May;80(9):2695–2698. doi: 10.1073/pnas.80.9.2695. [DOI] [PMC free article] [PubMed] [Google Scholar]
- Fowler R. G., Degnen G. E., Cox E. C. Mutational specificity of a conditional Escherichia coli mutator, mutD5. Mol Gen Genet. 1974;133(3):179–191. doi: 10.1007/BF00267667. [DOI] [PubMed] [Google Scholar]
- Glickman B. W. Spontaneous mutagenesis in Escherichia coli strains lacking 6-methyladenine residues in their DNA: an altered mutational spectrum in dam- mutants. Mutat Res. 1979 Jul;61(2):153–162. doi: 10.1016/0027-5107(79)90122-2. [DOI] [PubMed] [Google Scholar]
- Konrad E. B. Isolation of an Escherichia coli K-12 dnaE mutation as a mutator. J Bacteriol. 1978 Mar;133(3):1197–1202. doi: 10.1128/jb.133.3.1197-1202.1978. [DOI] [PMC free article] [PubMed] [Google Scholar]
- Leong P. M., Hsia H. C., Miller J. H. Analysis of spontaneous base substitutions generated in mismatch-repair-deficient strains of Escherichia coli. J Bacteriol. 1986 Oct;168(1):412–416. doi: 10.1128/jb.168.1.412-416.1986. [DOI] [PMC free article] [PubMed] [Google Scholar]
- Loeb L. A., Preston B. D. Mutagenesis by apurinic/apyrimidinic sites. Annu Rev Genet. 1986;20:201–230. doi: 10.1146/annurev.ge.20.120186.001221. [DOI] [PubMed] [Google Scholar]
- Lu A. L., Welsh K., Clark S., Su S. S., Modrich P. Repair of DNA base-pair mismatches in extracts of Escherichia coli. Cold Spring Harb Symp Quant Biol. 1984;49:589–596. doi: 10.1101/sqb.1984.049.01.066. [DOI] [PubMed] [Google Scholar]
- Miller J. H., Low K. B. Specificity of mutagenesis resulting from the induction of the SOS system in the absence of mutagenic treatment. Cell. 1984 Jun;37(2):675–682. doi: 10.1016/0092-8674(84)90400-8. [DOI] [PubMed] [Google Scholar]
- Miller J. H. Mutagenic specificity of ultraviolet light. J Mol Biol. 1985 Mar 5;182(1):45–65. doi: 10.1016/0022-2836(85)90026-9. [DOI] [PubMed] [Google Scholar]
- Scheuermann R., Tam S., Burgers P. M., Lu C., Echols H. Identification of the epsilon-subunit of Escherichia coli DNA polymerase III holoenzyme as the dnaQ gene product: a fidelity subunit for DNA replication. Proc Natl Acad Sci U S A. 1983 Dec;80(23):7085–7089. doi: 10.1073/pnas.80.23.7085. [DOI] [PMC free article] [PubMed] [Google Scholar]
- Shanabruch W. G., Behlau I., Walker G. C. Spontaneous mutators of salmonella typhimurium LT2 generated by insertion of transposable elements. J Bacteriol. 1981 Sep;147(3):827–835. doi: 10.1128/jb.147.3.827-835.1981. [DOI] [PMC free article] [PubMed] [Google Scholar]
- Topal M. D., Fresco J. R. Base pairing and fidelity in codon-anticodon interaction. Nature. 1976 Sep 23;263(5575):289–293. doi: 10.1038/263289a0. [DOI] [PubMed] [Google Scholar]
- Yanofsky C., Cox E. C., Horn V. The unusual mutagenic specificity of an E. Coli mutator gene. Proc Natl Acad Sci U S A. 1966 Feb;55(2):274–281. doi: 10.1073/pnas.55.2.274. [DOI] [PMC free article] [PubMed] [Google Scholar]